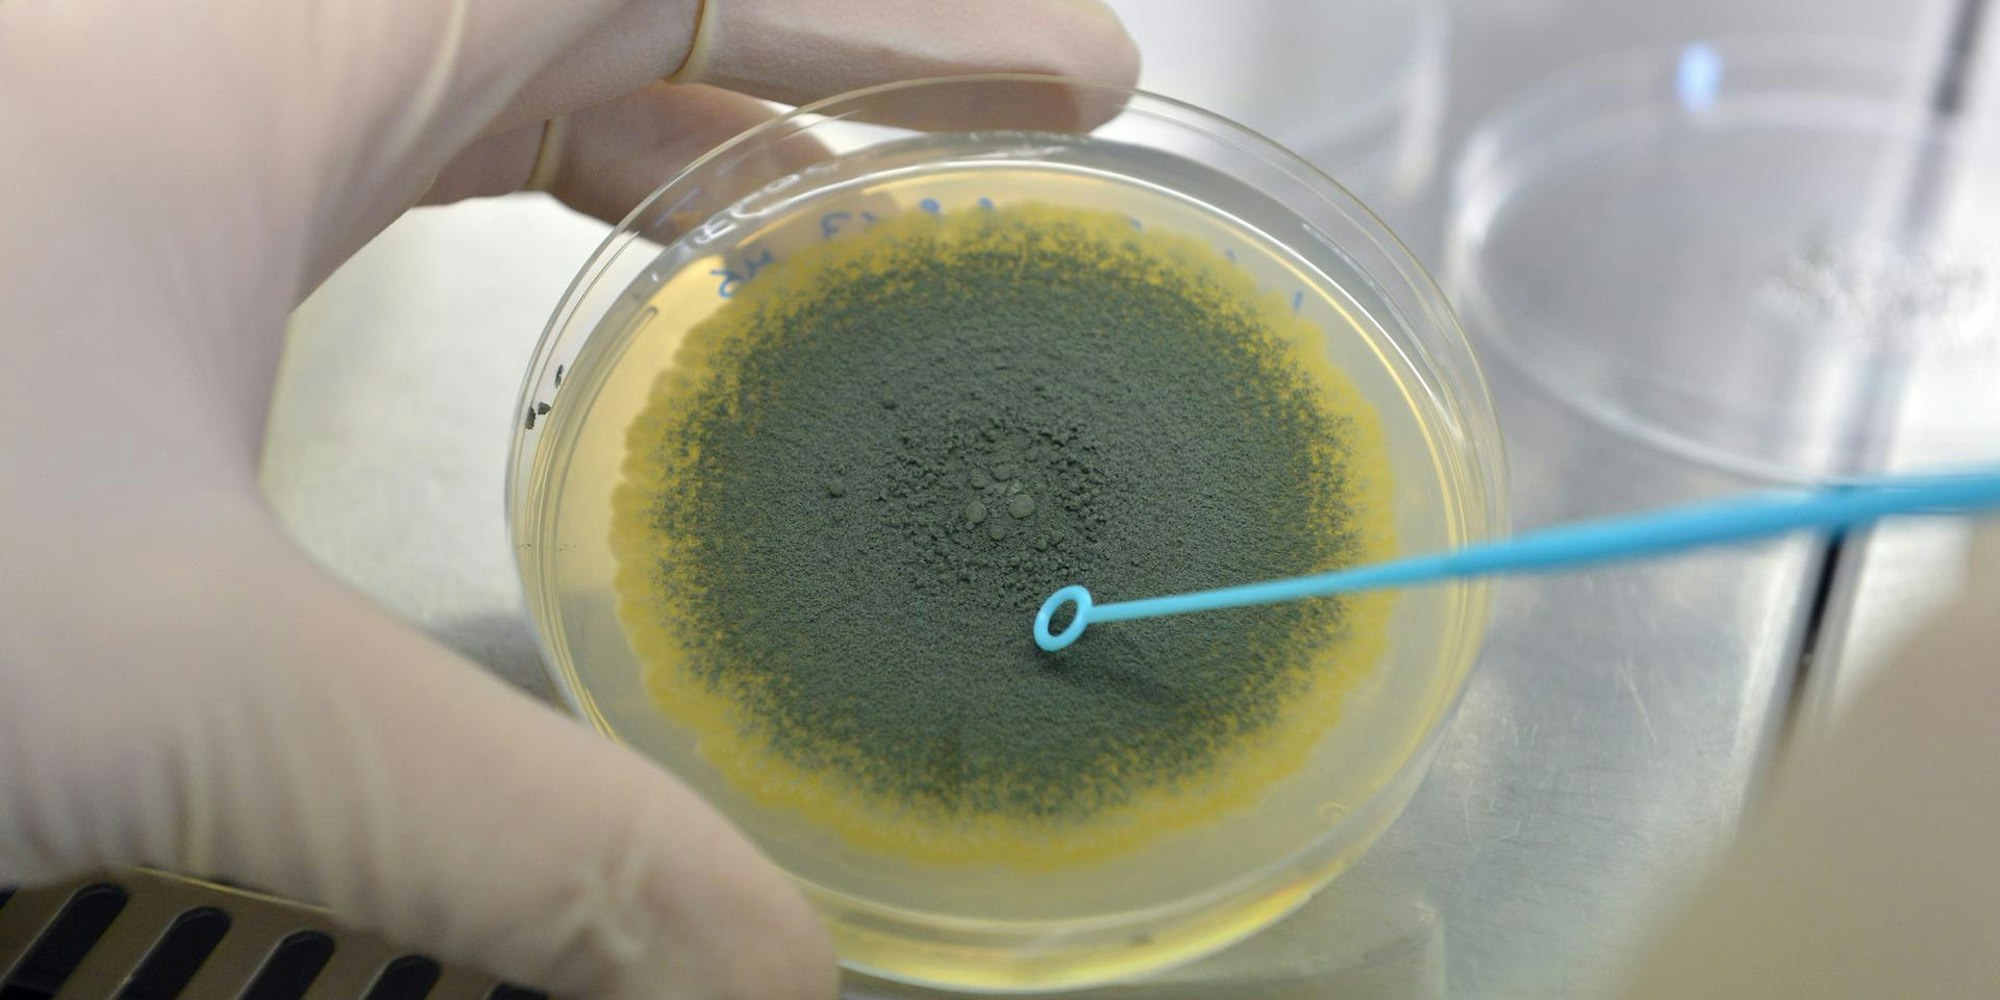

Übergangslösung gefundenFachgutachten entdeckt Schimmelpilz in Oberwiehler Awo-Kita
In der Oberwiehler Awo-Kita wurden bei Messungen der Raumluft Schimmelpilzsporen nachgewiesen. Die Stadt hat einen Gutachter eingeschaltet.
Copyright: picture alliance / dpa
Oberwiehl – Im Familienzentrum Eleonore Astfalck der Arbeiterwohlfahrt (Awo) in Wiehl-Oberwiehl liegt laut eines Fachgutachtens eine Belastung der Raumluft mit Schimmelpilzsporen vor. Dennoch könnte dem Gutachten zufolge die dortige Kindertagesstätte bis zu einer Sanierung weiter betrieben werden – unter der Voraussetzung häufigen Lüftens und des Betriebs von Luftfiltergeräten.
Das geht aus einer Mitteilung der Stadt Wiehl hervor, die sich in Abstimmung mit der Awo dennoch für einen anderen Weg entschieden hat: Innerhalb der kommenden Wochen soll eine Übergangslösung an anderem Standort geschaffen werden. Gleichzeitig ist vorgesehen, die Sanierung der Kita umgehend in Angriff zu nehmen, sodass die Zwischenlösung nur etwa ein halbes Jahr in Anspruch genommen werden muss.
Stadt Wiehl sucht nach neuem Kita-Standort
„Wir möchten schnell handeln, daher wird die Kita so bald wie möglich als Übergangslösung an einen anderen Standort verlagert“, wird Bürgermeister Ulrich Stücker zitiert. „Die Sorgen der Eltern nehmen wir sehr ernst und tragen dem Rechnung.“ Entsprechend habe die Stadt Wiehl in den vergangenen Tagen intensiv nach einem alternativen Standort gesucht, der schnell zur Verfügung steht. Das Ergebnis: Die Awo-Kita wird mit Start des Kita-Jahres am 9. August zunächst für eine Übergangszeit von wenigen Wochen im Oberwiehler Paul-Schneider-Haus weiter betrieben. Die Räume und die Umlage werden derzeit dafür hergerichtet.
Diese Lösung gilt so lange, bis ein Ausweichgebäude aus Con-tainerelementen mit größerem Raumangebot errichtet worden ist, in dem die meisten Kinder während der etwa sechsmonatigen Sanierungsphase ihr Domizil bekommen. Der Standort des Ausweichgebäudes wird auf dem Grundstück des Paul-Schneider-Hauses sein. Die Containerlösung bietet Platz für zwei Kita-Gruppen, zur Betreuung der dritten Gruppe steht weiter das Paul-Schneider-Haus zur Verfügung. Bis Mitte, Ende September 2022 soll das Ausweichgebäude in Betrieb gehen. Die notwendigen Vorarbeiten laufen bereits.
Das könnte Sie auch interessieren:
Gleichzeitig startet die Sanierung der regulären Kita, die so schnell wie möglich beendet werden soll. Zudem lädt die Stadt im August zu einem Elternabend ein, um Väter und Mütter zu informieren. „Jetzt kommt es vor allem darauf an, eine schnelle und gute Interimslösung zu verwirklichen, die dem Personal und den Eltern gesundheitliche Sorgen im Hinblick auf eine Pilzbelastung nimmt und eine unbedenkliche Umgebung bereitstellt“, sagt Stücker. (ar)